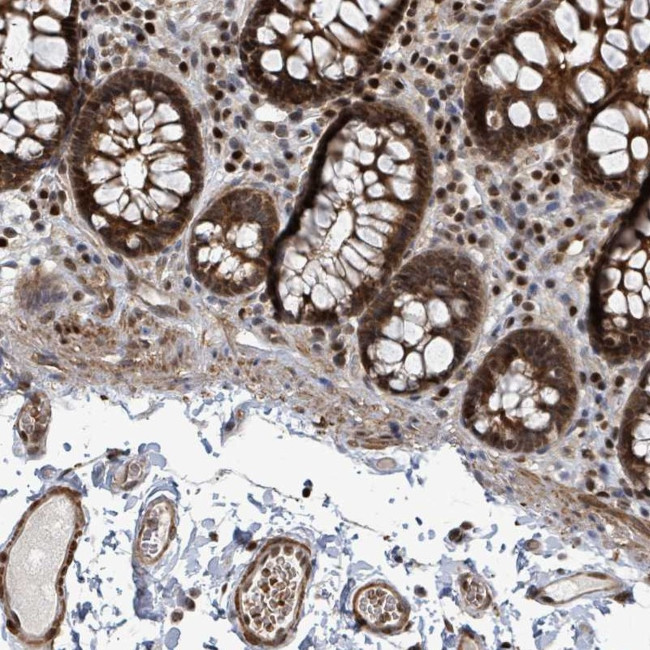
DNMT2 Antibody in Immunohistochemistry (Paraffin) (IHC (P))

Search
Invitrogen
DNMT2 Polyclonal Antibody
{{$productOrderCtrl.translations['antibody.pdp.commerceCard.promotion.promotions']}}
{{$productOrderCtrl.translations['antibody.pdp.commerceCard.promotion.viewpromo']}}
{{$productOrderCtrl.translations['antibody.pdp.commerceCard.promotion.promocode']}}: {{promo.promoCode}} {{promo.promoTitle}} {{promo.promoDescription}}. {{$productOrderCtrl.translations['antibody.pdp.commerceCard.promotion.learnmore']}}
产品信息
PA5-57884
种属反应
宿主/亚型
分类
类型
抗原
偶联物
形式
浓度
规格
纯化类型
保存液
内含物
保存条件
运输条件
RRID
产品详细信息
Immunogen sequence: RVLELYSGVG GMHHALRESC IPAQVVAAID VNTVANEVYK YNFPHTQLLA KTIEGITLEE FDRLSFDMIL MSPPCQPFTR IGRQGDMTDS RT
Highest antigen sequence identity to the following orthologs: Mouse - 87%, Rat - 86%.
靶标信息
CpG methylation is an epigenetic modification that is important for embryonic development, imprinting, and X-chromosome inactivation. Studies in mice have demonstrated that DNA methylation is required for mammalian development. This gene encodes a protein with similarity to DNA methyltransferases, but this protein does not display methyltransferase activity. The protein strongly binds DNA, suggesting that it may mark specific sequences in the genome. Alternative splicing results in multiple transcript variants encoding different isoforms.
仅用于科研。不用于诊断过程。未经明确授权不得转售。
篇参考文献 (0)
生物信息学
蛋白别名: DNA (cytosine-5)-methyltransferase-like protein 2; DNA cytosine-5 methyltransferase 2; DNA methyltransferase homolog HsaIIP; DNA methyltransferase-2; DNA MTase homolog HsaIIP; DNMT2; DNMT2b; DNMT2c; DNMT2d; DNMT2e; DNMT2f; homolog to yeast pmt1; M.HsaIIP; PuMet; RP11-406H21.1; tRNA (cytosine(38)-C(5))-methyltransferase; tRNA (cytosine-5-)-methyltransferase; unnamed protein product
基因别名: DMNT2; DNMT2; MHSAIIP; PUMET; RNMT1; TRDMT1
UniProt ID: (Human) O14717
Entrez Gene ID: (Human) 1787